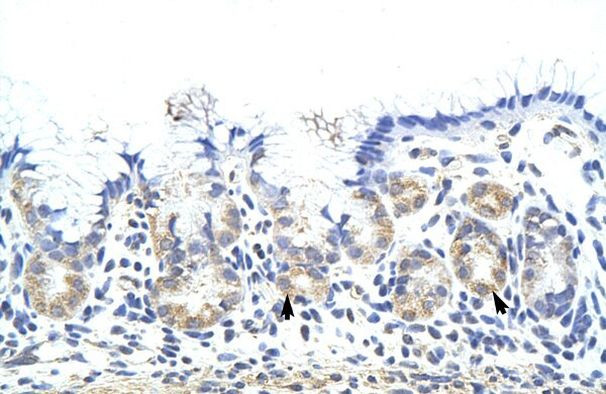
ZNF322A Antibody in Immunohistochemistry (IHC)

Search
Invitrogen
ZNF322A Polyclonal Antibody
{{$productOrderCtrl.translations['antibody.pdp.commerceCard.promotion.promotions']}}
{{$productOrderCtrl.translations['antibody.pdp.commerceCard.promotion.viewpromo']}}
{{$productOrderCtrl.translations['antibody.pdp.commerceCard.promotion.promocode']}}: {{promo.promoCode}} {{promo.promoTitle}} {{promo.promoDescription}}. {{$productOrderCtrl.translations['antibody.pdp.commerceCard.promotion.learnmore']}}


Please note: We are reviewing Western blot images included in the antibody testing data in our catalog, including those provided by third parties. Unless expressly labeled or annotated as “raw-unedited”, Western blot images included in the antibody testing data in our catalog may have been edited, optimized or otherwise adjusted for presentation.
产品信息
PA5-41636
种属反应
宿主/亚型
分类
类型
抗原
偶联物
形式
浓度
规格
纯化类型
保存液
内含物
保存条件
运输条件
RRID
产品详细信息
Peptide sequence: YTVCDKSFHQ SSALLQHQTV HIGEKPFVCN VSEKGLELSP PHASEASQMS
Sequence homology: Cow: 85%; Dog: 100%; Goat: 92%; Horse: 100%; Human: 100%; Mouse: 79%; Pig: 92%; Rabbit: 92%; Rat: 79%
靶标信息
ZNF322 contains four exons and spans 23.2kb in chromosome 6p22.1 region, and transcribes a 2.7kb mRNA that encodes a protein with 402 amino acid residues.Through northern blot analysis, ZNF322 was shown to be expressed in every human tissue examined at adult stage and during embryonic developmental stages from 80 days to 24 weeks. When ZNF322 was overexpressed in COS-7 cells, ZNF322-EGFP fusion protein is detected in the nucleus and cytoplasm. Reporter gene assays show that ZNF322 is a transcriptional activator. Furthermore, overexpression of ZNF322 in COS-7 cells activates the transcriptional activity of SRE and AP-1. Together, these results suggest that ZNF322 is a member of the zinc-finger transcription factor family and may act as a positive regulator in gene transcription mediated by the MAPK signaling pathways.
仅用于科研。不用于诊断过程。未经明确授权不得转售。